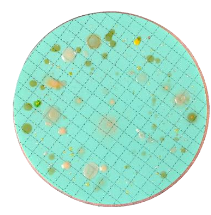
Nutrient Pad Sets - m-TGE-NPS

Female Run Tee
Price range: $102.00 through $123.45
Item Name: Female Run Tee
Manufacturer: Truelok
- Description
- Size Guide
- Additional information
- Vendor Info
- More Products
Description
Female Run Tee
|
Truelok Ordering Number |
T Tube O.D. |
P NPT Female Pipe Size |
Ax |
C |
D |
E Minimum Opening |
F Wrench Pad |
G Hex Flat |
Hx |
Hy |
|
|
inch |
inch |
inch |
inch |
inch |
inch |
inch |
inch |
inch |
inch |
|
FRT-125-125-N |
1/8 |
1/8 |
0.97 |
0.60 |
0.50 |
0.09 |
5/8 |
7/16 |
0.71 |
0.75 |
|
FRT-250-125-N |
1/4 |
1/8 |
1.06 |
0.70 |
0.60 |
0.19 |
5/8 |
9/16 |
0.77 |
0.75 |
|
FRT-250-250-N |
1/4 |
1/4 |
1.17 |
0.70 |
0.60 |
0.19 |
13/16 |
9/16 |
0.88 |
0.88 |
|
FRT-375-250-N |
3/8 |
1/4 |
1.23 |
0.76 |
0.66 |
0.28 |
13/16 |
11/16 |
0.94 |
0.88 |
|
FRT-500-375-N |
1/2 |
3/8 |
1.42 |
0.86 |
0.90 |
0.41 |
15/16 |
7/8 |
1.02 |
0.88 |
|
FRT-500-500-N |
1/2 |
1/2 |
1.57 |
0.86 |
0.90 |
0.41 |
1 |
7/8 |
1.17 |
1.12 |
|
FRT-750-500-N |
3/4 |
1/2 |
1.57 |
0.86 |
0.96 |
0.62 |
1-1/16 |
1-1/8 |
1.17 |
1.12 |
|
FRT-750-750-N |
3/4 |
3/4 |
1.76 |
0.86 |
0.96 |
0.62 |
1-1/4 |
1-1/8 |
1.36 |
1.25 |
|
FRT-1000-750-N |
1 |
3/4 |
1.93 |
1.04 |
1.5 |
0.88 |
1-27/64 |
1-1/2 |
1.45 |
1.25 |
|
FRT-1000-1000-N |
1 |
1 |
1.98 |
1.04 |
1.5 |
0.88 |
1-1/16 |
1-1/2 |
1.63 |
1.5 |
Female Run Tee

Material:
Truelok standard Compression Tube Fittings are manufactured by using SS316 Bar Stock in accodance with ASTM A-479 and SS316 Forging in accordance with ASTM A-182. Fittings in other materials are available at customer’s request.
Operating Temperature:
Truelok Compression Tube Fittings provide safe and reliable performance from cyrogenic temperature to high temperature upto 380 °C.
Working Pressure:
The maximum working pressure of standard Compression Tube Fittings when used in conjunction with annealed SS316 seamless tubing per ASTM A-213 or equivalent is shown below:
| Tube O.D. (inch) |
Wall Thickness (inch) | |||||
| 0.020 | 0.028 | 0.035 | 0.049 | 0.065 | 0.083 | |
| 1/8″ | 6863 | 9967 | 12641 | |||
| 1/4″ | 4600 | 5891 | 8602 | 11688 | ||
| 3/8″ | 3777 | 5460 | 7571 | |||
| 1/2″ | 2768 | 3976 | 5423 | 7162 | ||
Additional information
| SIZE | 1/8" x 1/8", 1/4" x 1/8", 1/4" x 1/4", 3/8" x 1/4", 1/2" x 3/8, 1/2" x 1/2" |
|---|